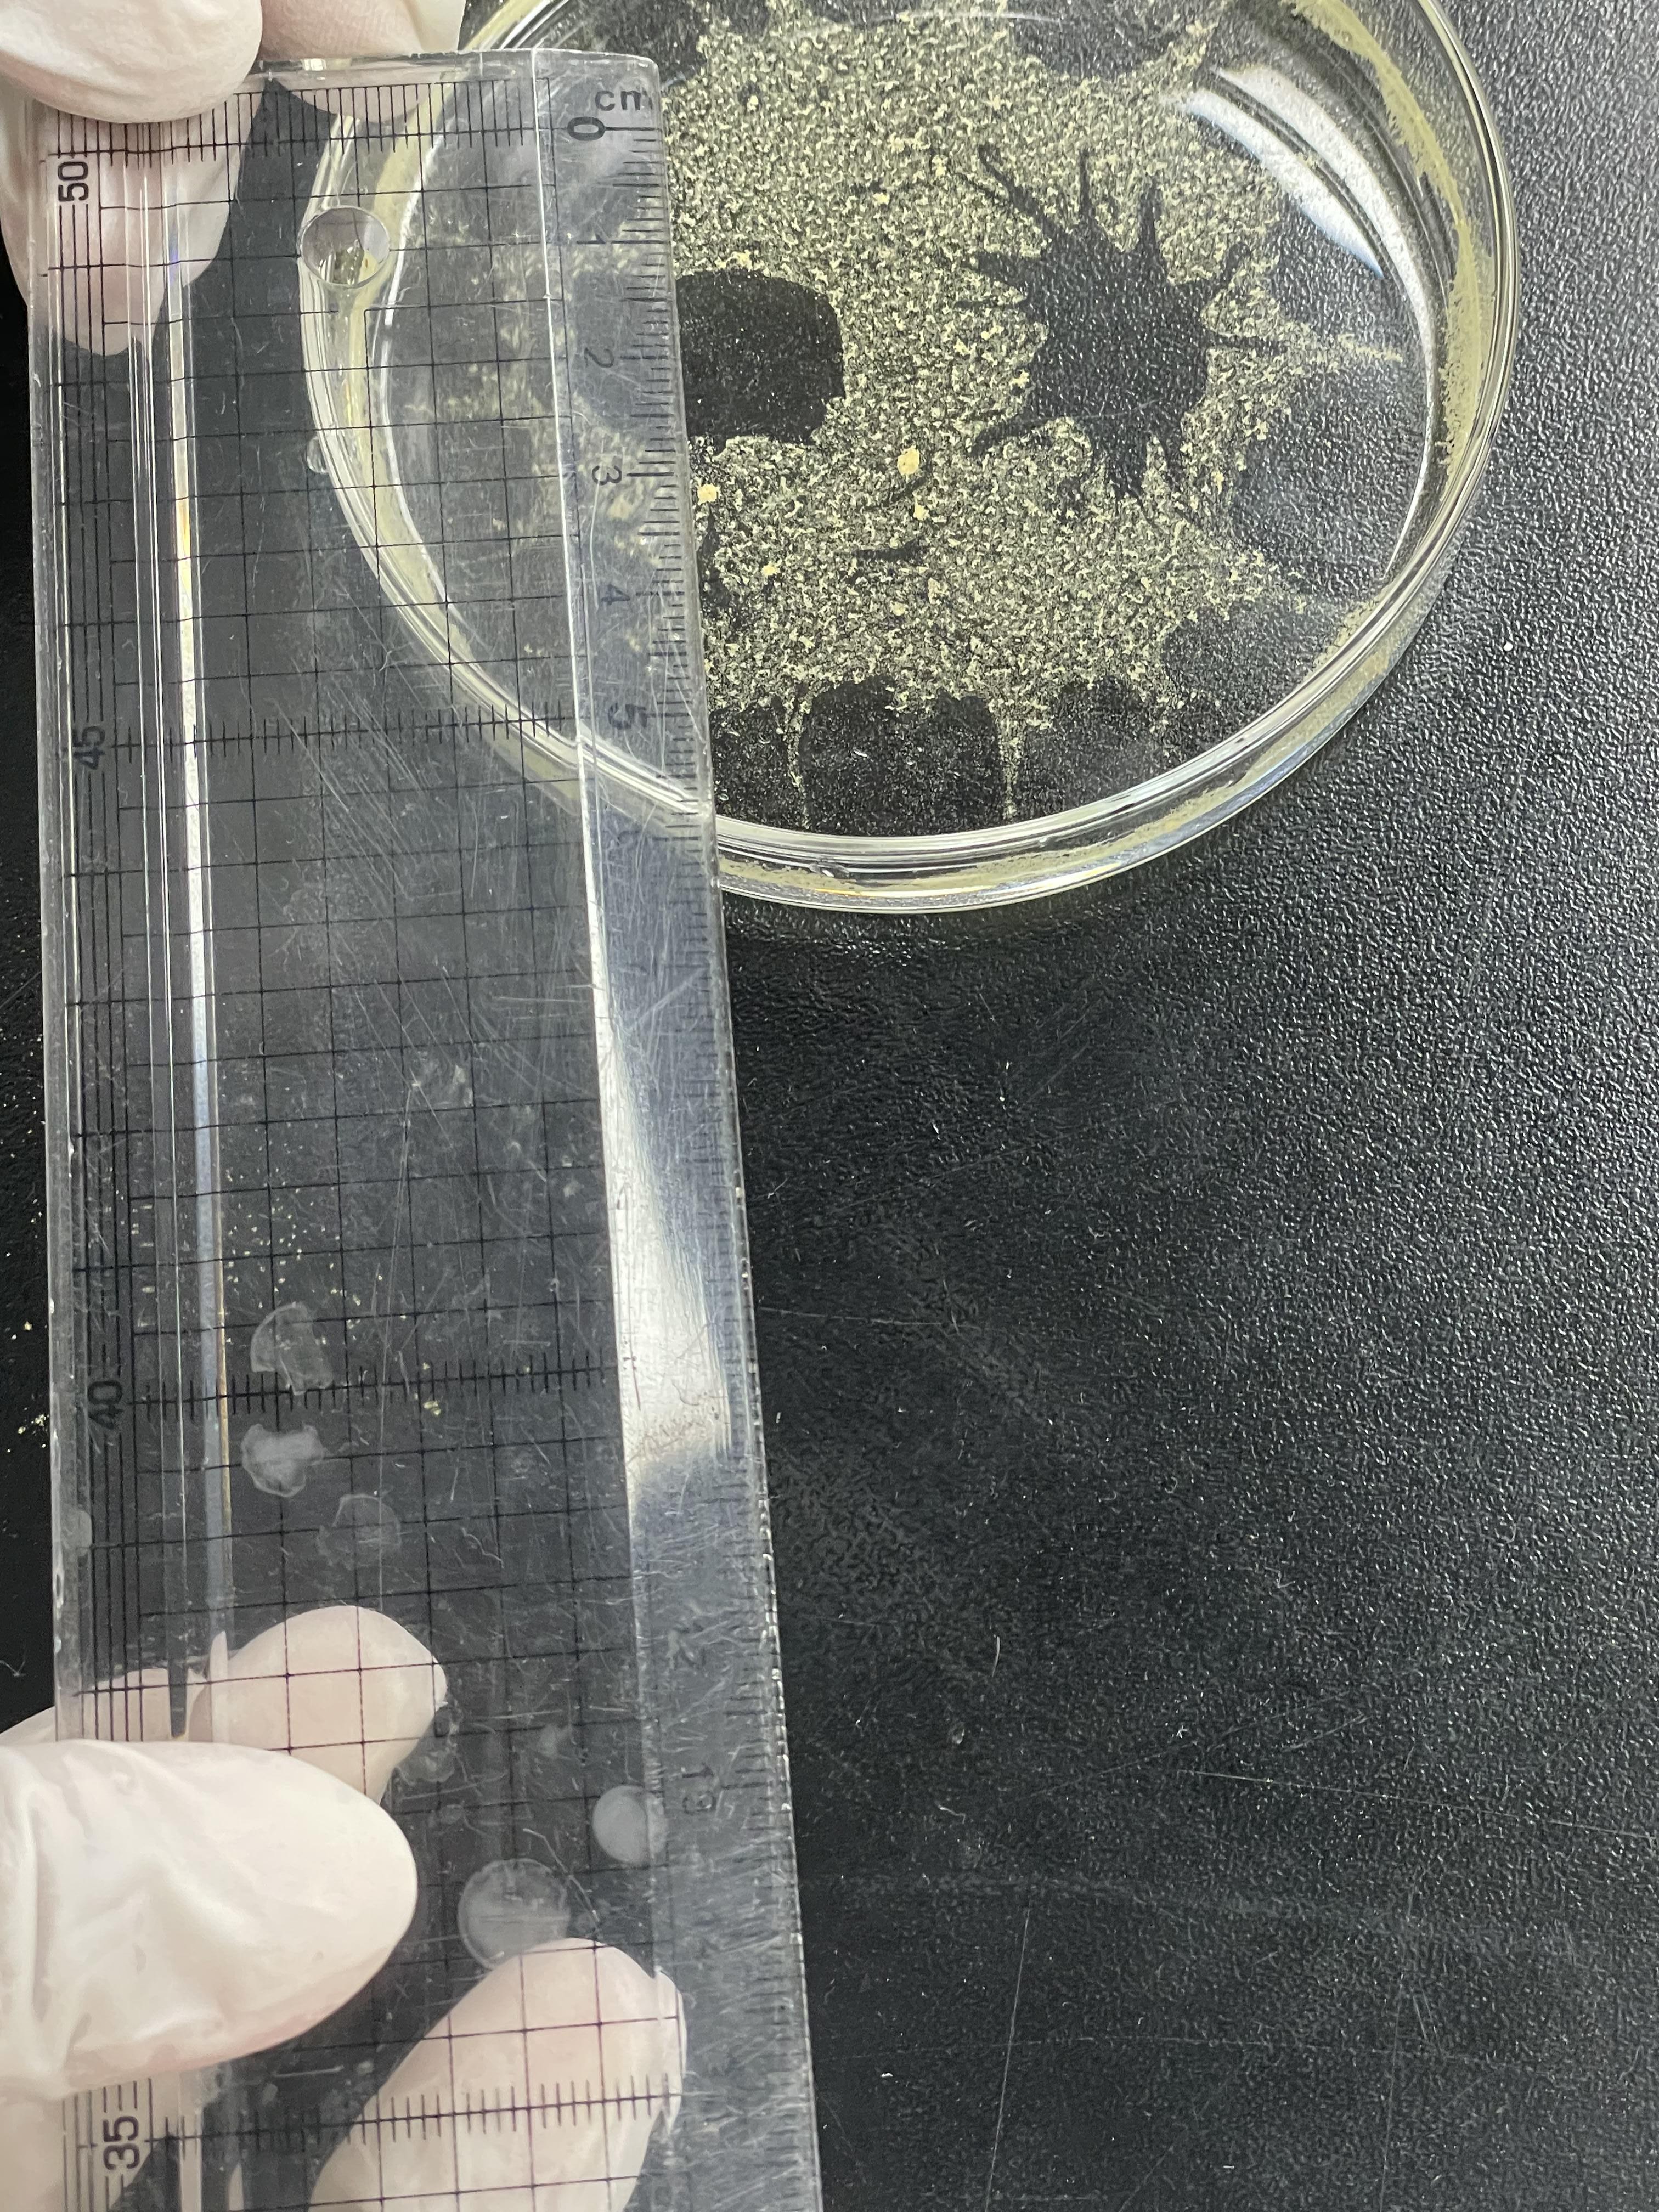
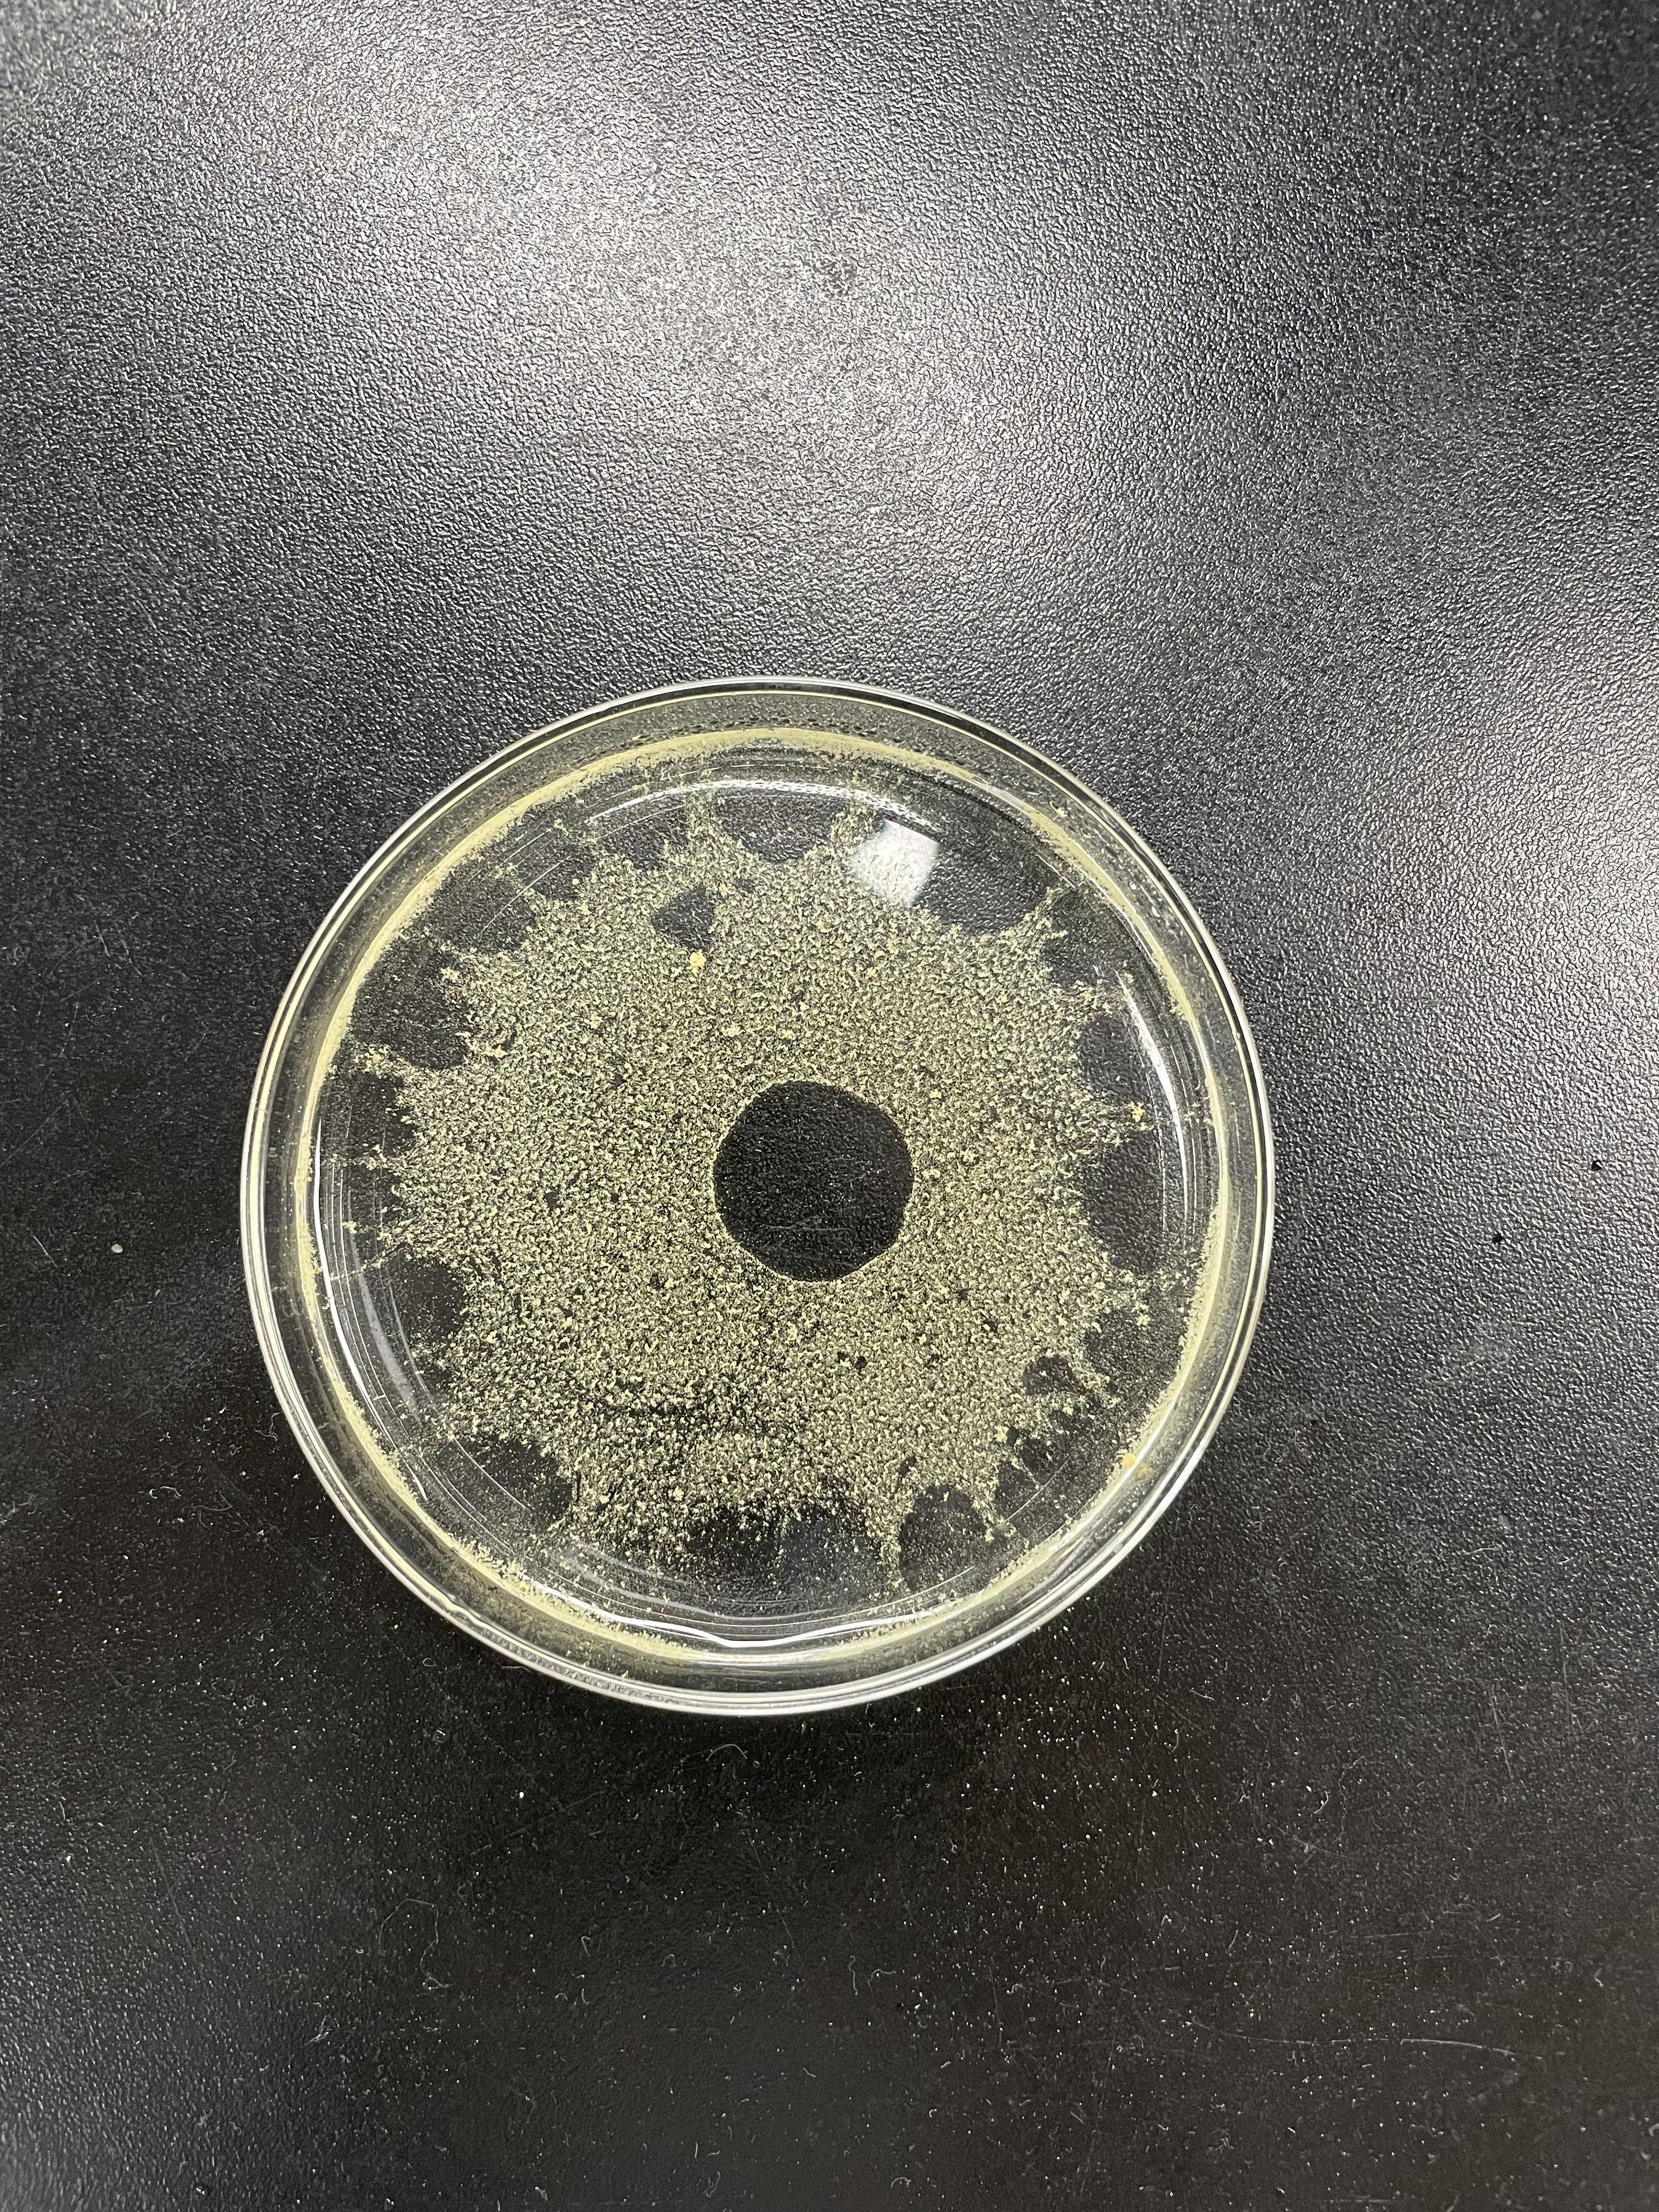
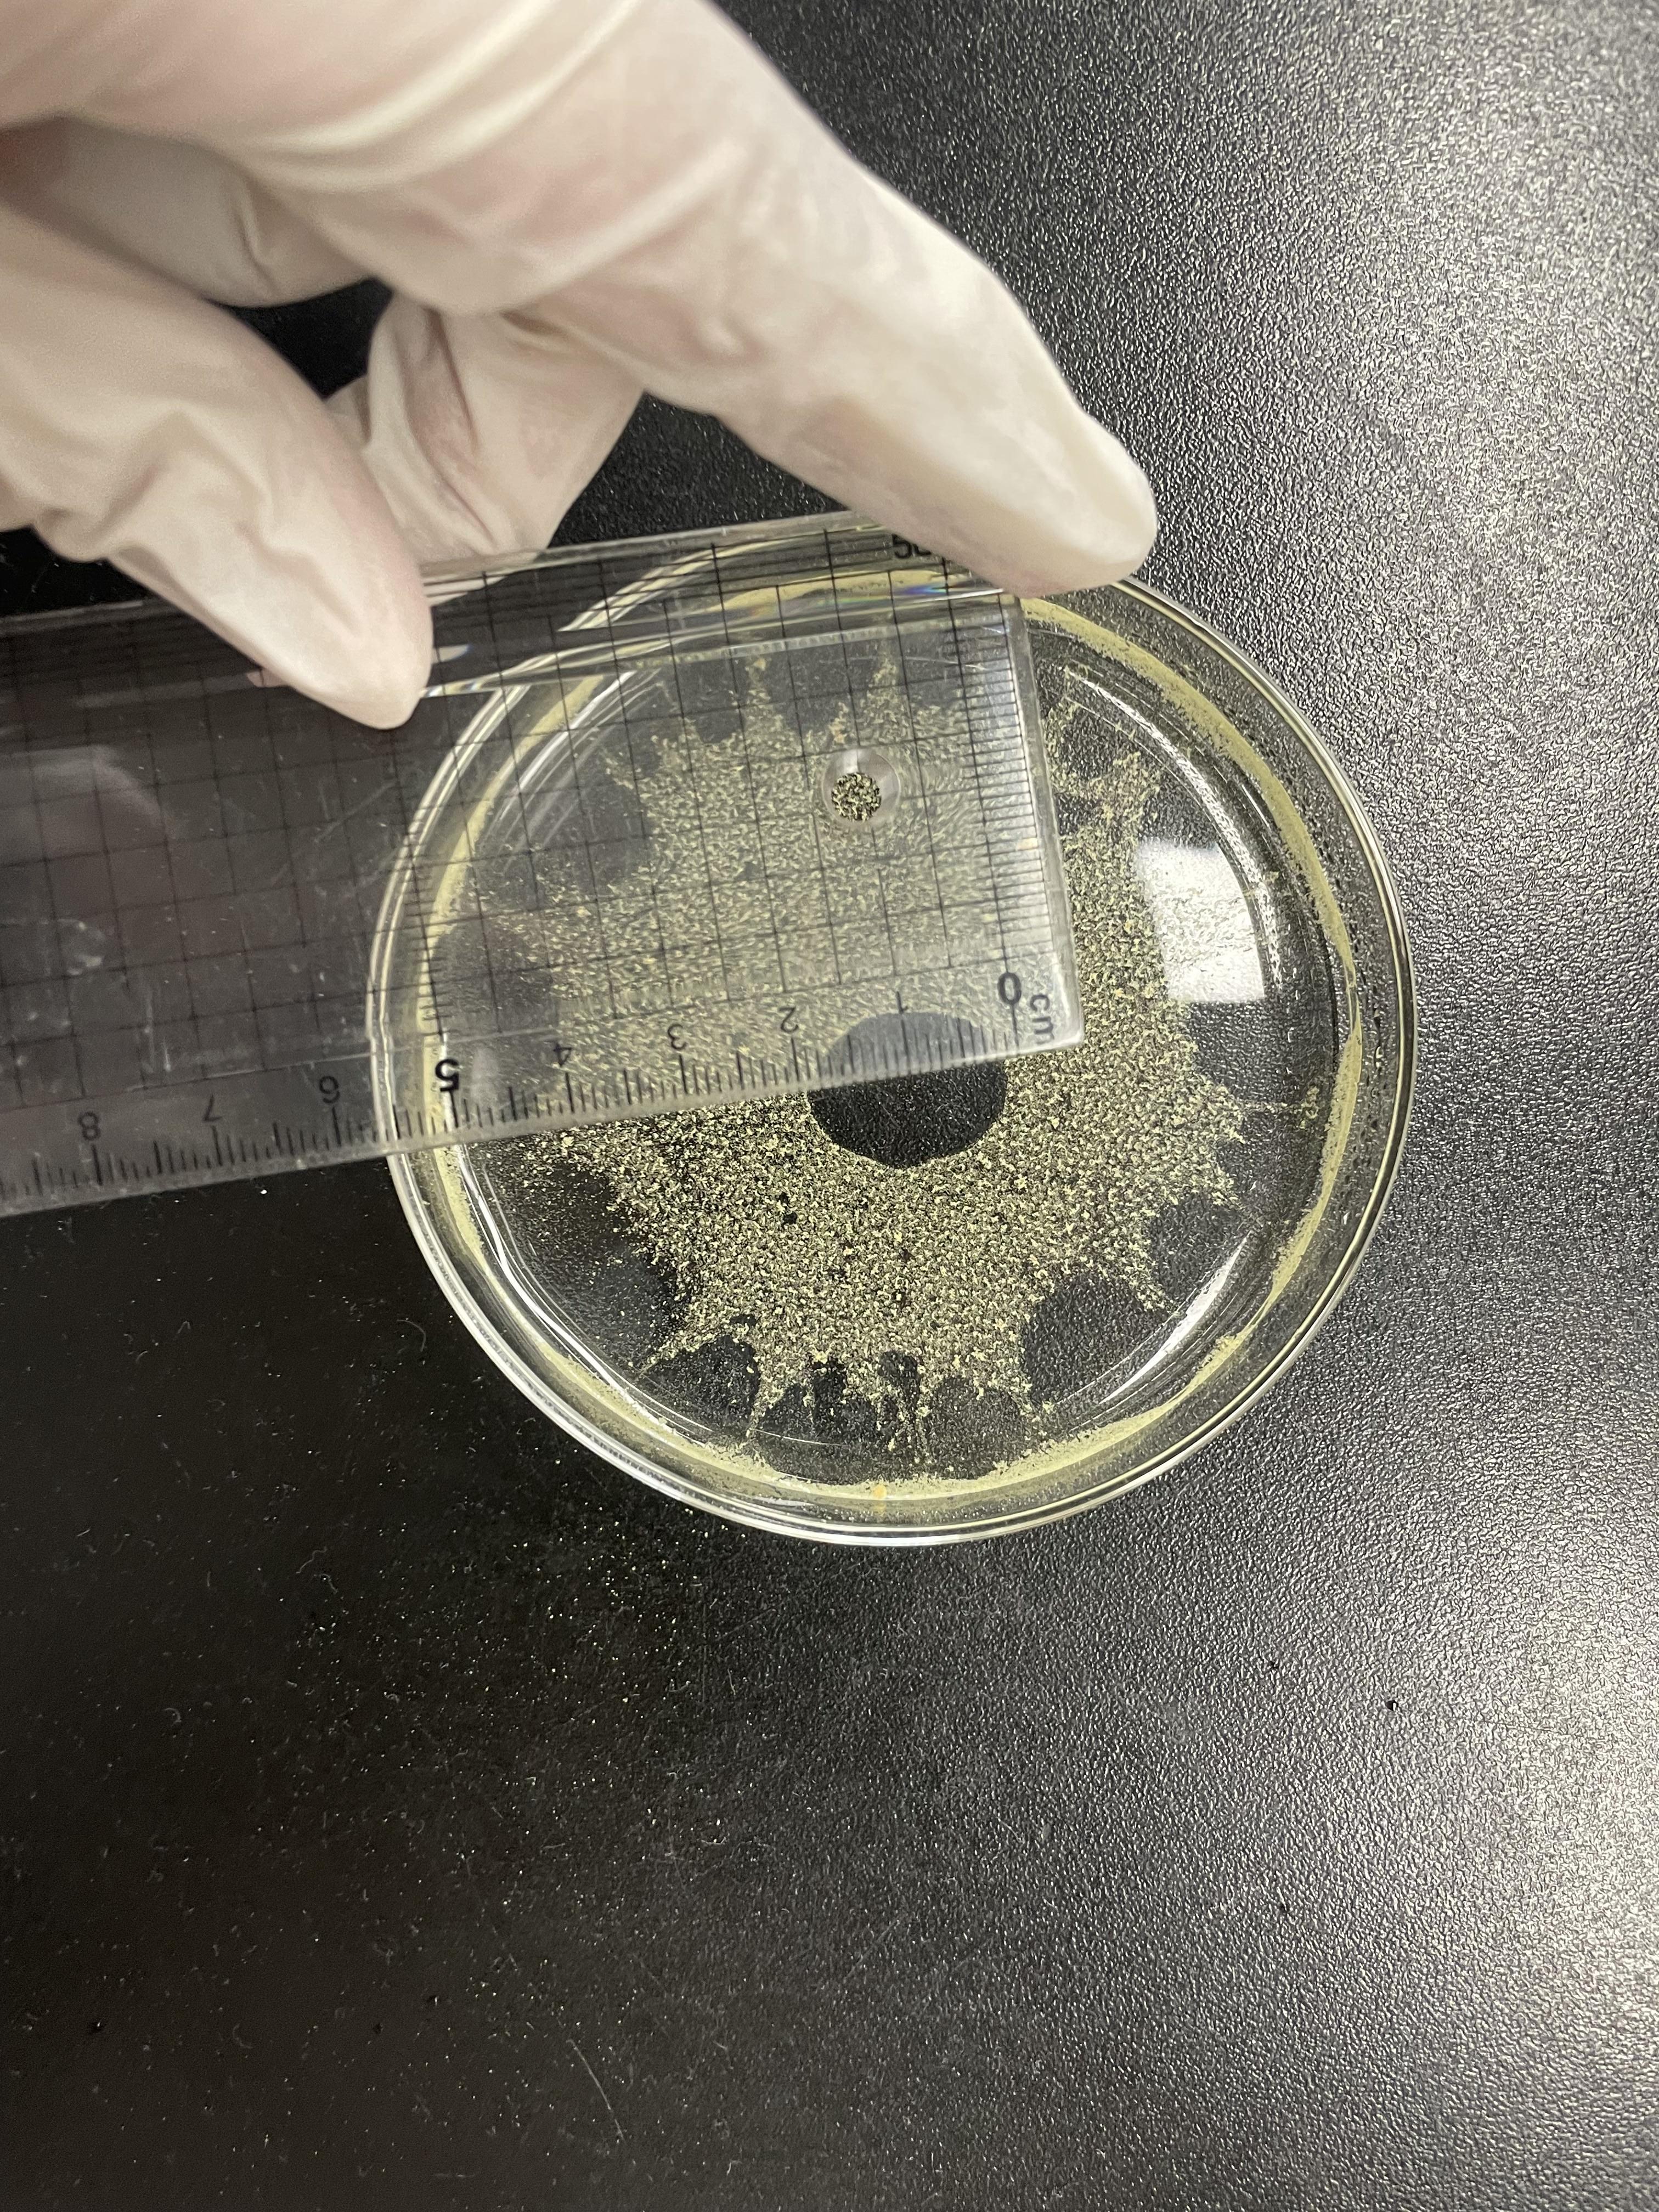

1. 실험 목적
물 표면에 퍼지면서 단층 막을 형성하는 스테아르산의 성질을 이용해서 몰 (mole)을 정의 하는데 필요한 아보가드로수를 구해본다.
2. 실험 이론
물 (H2O)은 이중 극자의 성질을 갖고 있는 극성 분자이다. NaCl과 같은 이온 화합물은 단 위 전하, 즉 Na+와 Cl-로 완전하게 분리되어 있으나, 극성 화합물은 전하가 부분적으로 분리 되어 있다. (δ;델타기호로 표시) 극성 분자들 끼리는 서로 끌어당기는데, 한 분자의 이중 극 자의 양극 (δ+)끝이 다른 분자의 이중 극자의 음극 (δ-)끝을 당기게 된다. 그래서 물은 이중 극자를 지닌 포름산 (H-COOH)을 녹일 수 있으나, 부탄 (C4H10)과 같이 이중 극자가 없는 물 질은 녹이지 못한다. 만약 이들 성질을 모두 지닌 분자를 물 표면에 가져오면 분자의 극성 부분은 표면에 끌릴 것이며, 비극성 부분은 반발 할 것이다. 그런데 비극성 부분이 극성 부 분보다 대단히 크다면 그 분자는 물에 녹지 않을 것이며, 탄소 분자들끼리의 반데르발스 힘 에 의해 긴 탄소사슬은 표면에 서게 될 것이다.
이 실험에서 사용하는 스테아르산 (Stearic acid)은 바로 위에서 설명한 행동을 보인다. 스 테아르산은 총 18개의 탄소를 갖고 있으며, 양 끝에 카복실기(-COOH)로 되어 있는 극성과 메틸기(-CH3)가 붙어 있는 비극성 꼬리를 가지고 있다. 기름처럼 물에 녹지 않는 물질은 무 극성 탄화수소 사슬에 둘러싸이게 되고, 극성을 가진 카복실기는 물에 잘 녹게 된다.
스테아르산을 헥세인에 녹여 물 위에 떨어뜨리면 극성을 가진 카복실기는 물에 잘 달라붙 지만 무극성인 탄화수소 사슬은 물과 잘 접촉하지 않으려는 경향이 있다.
따라서 물 위의 헥세인이 모두 증발하면 스테아르산의 카복실기는 물 쪽으로 향하고 탄화수 소 사슬은 물 층 위로 서 있는 단분자층, 즉 단층막(monolayer)이 형성된다.

앞에서 이미 언급한 바와 같이 스테아르산 분자는 18개의 탄소 원자가 연결되어 있다. 이 원자들이 서로 연결된 작은 입방체라고 가정하여 탄소 입방체의 한 모서리의 길이를 구할 수 있고, 모서리 길이의 세제곱은 탄소원자의 부피가 된다.
탄소 1몰의 질량은 12.011g 이고, 탄소 원자가 촘촘히 쌓여서 만들어진 다이아몬드의 밀도 (3.51 g/cm3)를 이용하면 탄소 원자 1몰이 차지하는 몰 부피(Vmol)을 쉽게 계산 할 수 있다. (다이아몬드는 탄소 원자가 촘촘히 쌓여진 입방체로 되어 있다고 가정한다)
아보가드로 수 만큼의 분자가 차지하는 부피는 바로 1몰의 부피이므로 아보가드로수는 다 음 계산으로부터 얻을 수 있다.

3. 실험방법
- 농도를 알고 있는 준비 된 스테아르산 용액(농도 : 0.035g/L)으로 3mL 이내를 사용하여 눈금실린더 (10mL)와 스포이드를 헹군다.
- 눈금실린더에 3mL의 스테아르산 용액을 채우고 눈금실린더 부피가 1mL 증가 될 때 까 지 스포이드로 스테아르산 용액을 한 방울씩 떨어뜨린다. 1mL 의 방울 수를 정확히 세 어 이 용액 한 방울의 부피를 구하고, 이것을 2회 더 반복한다. (총3회)
- 페트리 접시에 물을 충분히 채우고, 수면이 잔잔해 질 때까지 기다린다.
- 시약 스푼을 이용하여 송화 가루를 페트리 접시 중심에 소량 뿌려준다.
- 스테아르산 용액을 스포이드에 넣어서 송화 가루가 퍼져있는 한 가운데에 한 방울 떨어 뜨린다. (스테아르산이 퍼지면서 생기는 원형 기름 막의 경계면을 쉽게 구별 할 수 있을 것이다)
- 원형으로 퍼진 단층 막의 직경을 측정한다. 원형이 아닌 경우 대각선 방향의 길이를 여러 번 측정해서 평균값을 얻는다. 3)~6)의 과정을 2회 더 반복한다. (총3회)
- 농도가 다른 스테아르산의 용액(0.070g/L)에 대하여 1)~6)의 실험을 반복한다.
주의 사항
스포이드로 방울을 떨어뜨릴 때 수직으로 눈금실린더에 떨어뜨린다.
(크게 한 방울씩) - 스포이드를 잡는 각도가 방울 수와 크기에 영향을 준다
(피펫의 경우, 수직에서 45도 벗어나면 30% 정도 방울 수가 적어짐) 송화가루를 얇게 2~3번 정도 뿌린다.
물 표면에 스테아르산 용액을 가하기 전에 스포이드를 이 용액으로 2~3번 씻어낸다.
⇒ 그렇지 않으면 헥세인이 증발하기 시작하여 스포이드 끝에 스테아르산의 진한 용액이
남아 있을 수 있다. 따라서 첫 방울에 더 많은 스테아르산이 포함 될 수 있다. 스테아르산 한 방울을 물 표면에 떨어뜨릴 때, 물 표면으로부터 2~3cm높이에서 살짝 떨어뜨린다.
⇒ 스테아르산의 모양이 원형을 유지하며, 단층 막의 형성이 잘 될 수 있도록 하기 위함
4. 기구와 시약
페트리 접시 (Petri dish), 눈금 실린더 (10mL), 증류수, 스포이드, 송화 가루, 비커 (50mL, 2 개), 스테아르산 (Stearic acid) 용액, 자, 시약 스푼 (spetula), 공학용 계산기
실험과정

5. 실험결과




'일반화학실험 > 화학및 실험1(실험)' 카테고리의 다른 글
| [화학및 실험1] 4주차 결과보고서, 마그네슘 연소 반응을 이용한 산소의 원자량 결정 (1) | 2023.04.30 |
|---|---|
| [화학및 실험1] 4주차 예비보고서, 마그네슘 연소 반응을 이용한 산소의 원자량 결정 (0) | 2023.04.28 |
| [화학및 실험1] 3주차 예비보고서, 스테아르산의 단층막을 이용한 아보가드로수의 결정 (0) | 2023.04.27 |
| [화학및 실험1] 2주차 결과보고서, 탄산염들의 CO2 생성반응을 통한 일정성분비의 법칙 확인 (0) | 2023.04.27 |
| [화학및 실험1] 2주차 예비보고서, 탄산염들의 CO2 생성반응을 통한 일정성분비의 법칙 확인 (1) | 2023.04.27 |